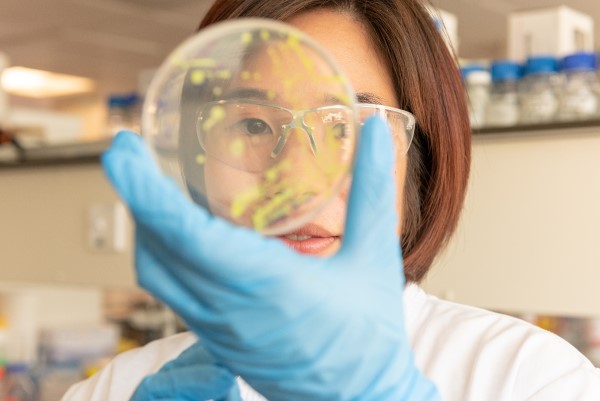
A woman with a petri dish

Impact for the REF

Impact for the Research Excellence Framework
What is the Research Excellence Framework (REF)?
The Research Excellence Framework (REF) is the UK’s system for assessing the quality of research in UK Higher Education institutions. It is assessed by the four UK higher education funding bodies: Research England, the Scottish Funding Council (SFC), the Higher Education Funding Council for Wales (HEFCW) and the Department for the Economy, Northern Ireland (DfE).
What is the REF’s purpose?
The aim of the research assessment is to secure the continuation of a world-class, dynamic and responsive research base across the full academic spectrum within UK higher education. The exercise provides accountability for public investment in research and offers evidence of the benefits of this research and investment. The results of the REF inform the allocation of future public funding for research.
The REF was first carried out in 2014, and the next one is scheduled for 2029 (postponed from the initial date of 2028).
The three assessment elements for REF 2029 are:
- Strategy, People, and Research Environment (20% weighting)
- Contribution to Knowledge and Understanding (55% weighting)
- Impact and Engagement (25% weighting)
Learn more about how the REF works and how we prepare using the links below:

Impact in the REF
Find out more about how research impact is assessed in the REF and Warwick's most recent performance.
Resources
Take a look at our resources on developing and collating impact for REF submission - including previous examples of Impact Case Studies.

